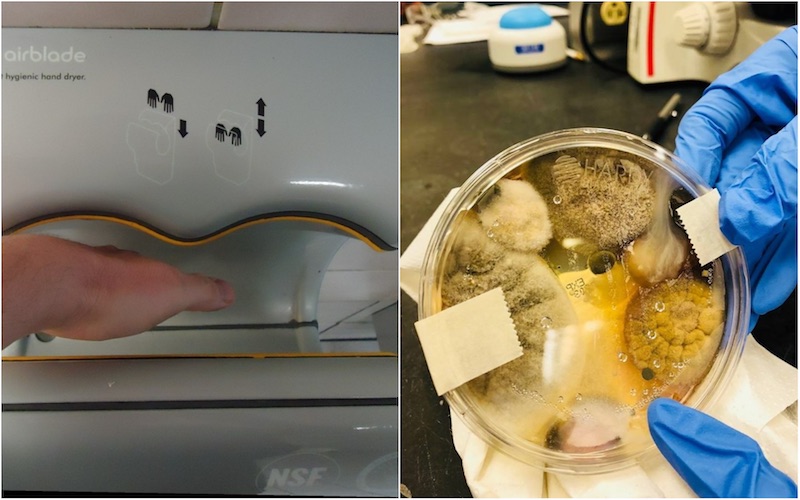
Photo: Wikimedia Commons; Nichole Ward

The advent of jet hand dryers in our public toilets seemed like the next logical evolution in sanitary technology. An alternative to rickety hand dryers that simply blew hot air on your palms instead of, you know, drying them, here was a super-fast, efficient way to get rid of damp hands. Assuming that you wash your hands after using the restroom, of course.
But thanks to an experiment conducted by a Californian woman by the name of Nichole Ward, you might never want to slot your hands into those things ever again.
In a Facebook post that went massively viral worldwide, Ward claims that she held up a Petri dish to a Dyson Airblade Hand Dryer in a public bathroom for three minutes before incubating the dish for a few days. The results are nasty — Ward wrote that the petri dish grew several strains of “possible pathogenic fungi and bacteria”, and it’s these very strains that we’re apparently swirling around our hands when we dry them.
Perhaps the abominable results of the experiment shouldn’t come as a surprise — Dyson Airblade hand dryers (and presumably other similar devices from other brands) were found to spread 60 times more germs than standard air dryers, according to research published in the Journal of Applied Microbiology in 2016. The jet hand dryers’ intense blasts of air were found to be capable of spreading viruses up to three meters across a bathroom, while standard driers spread viruses at up to 75cm and hand towels only 25 cm.
So yeah, the next time you’re using one of those things in public bathrooms here, you might actually be walking out with bug-infected palms instead of clean ones. You should still wash your hands with soap after using the bathroom though.